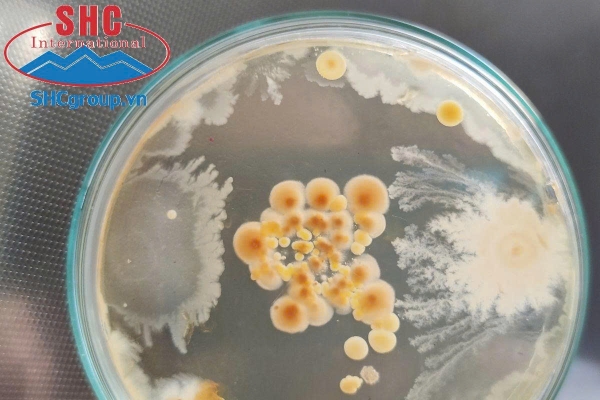
Diệt khuẩn để ngăn chăn các mầm bệnh xuất hiện trong ao nuôi.

Trong môi trường ao nuôi, mặc dù đã xử lý cẩn thận ban đầu nhưng vi khuẩn luôn có khả năng xuất hiện và tấn công tôm gây nên một số bệnh khó điều trị, từ đó tôm mất sức đề kháng dẫn đến chết. Chính vì vậy vấn đề diệt khuẩn luôn được bà con quan tâm đến. Diệt khuẩn như thế nào là đúng cách để không ảnh hưởng đến tôm, mời bà con tham khảo bài viết dưới đây nhé!

Ép khuẩn và diệt khuẩn có giống nhau hay không ?
Vi khuẩn chia thành hai loại chính: Vi khuẩn có lợi và vi khuẩn gây hại.
Vi khuẩn có lợi là những vi khuẩn có khả năng phân hủy chất hữu cơ trong ao nuôi, giúp cải thiện chất lượng nước và tăng sản lượng tôm. Tuy nhiên, vi khuẩn gây hại cũng tồn tại trong ao tôm và có thể gây ra các bệnh nhiễm trùng cho tôm, gây thiệt hại về kinh tế.
Vi khuẩn trong nước là một phần của chuỗi thức ăn trong hệ sinh thái và có vai trò quan trọng trong kiểm soát vệ sinh ao. Khi có sự thay đổi trong hệ sinh thái, cân bằng này có thể bị mất, dẫn đến sự phát triển quá mức của các loại vi khuẩn có hại, đặc biệt là nhóm Vibrio, gây ra bệnh hoại tự gan tụy trên tôm.
Diệt khuẩn ao tôm là diệt những loại vi sinh vật bất lợi cho Tôm và môi trường nuôi Tôm. Bởi trong quá trình nuôi, các loại vi sinh vật và mầm bệnh có hại sẽ luôn tiềm ẩn, gây bất lợi cho quá trình sinh trưởng, phát triển của tôm và môi trường ao nuôi.
Diệt khuẩn ao tôm đúng cách và an toàn sẽ làm giảm đáng kể các mầm bệnh trong suốt vụ nuôi và tăng khả năng thành công hơn 70%. Bên cạnh việc sử dụng diệt khuẩn trong ao nuôi tôm thẻ bằng acid hữu cơ và Nano bạt, ta còn có thể phối hợp sử dụng vi sinh, xi phông đáy,… để cải thiện toàn diện chất lượng nước trong ao nuôi, từ đó có một quy trình quản lý môi trường ao nuôi hiệu quả.
Từ đó, ta có thể nói ép khuẩn là một dạng diệt khuẩn tuy nhiên sẽ không sử dụng các hóa chất mạnh như diệt khuẩn thông thường. Điều này sẽ gây ảnh hưởng lên cả vi khuẩn có lợi hỗ trợ tôm trong ao nuôi. Ép khuẩn chỉ đơn giản là khống chế vi khuẩn có hại ngừng sinh sôi nhiều hơn.
Những giai đoạn phù hợp cho diệt khuẩn
– Diệt khuẩn giai đoạn chuẩn bị thả giống: Ở giai đoạn này, người nuôi nên tiến hành bơm nước vào ao qua màn lọc để giảm bớt trứng, ấu trùng mầm bệnh xâm nhập vào ao. Chạy quạt nước sau 5-7 ngày để trứng, ấu trùng các mầm bệnh nở rồi mới xử lý bằng thuốc diệt khuẩn, sát trùng nước.
– Diệt khuẩn giai đoạn tôm nhỏ đến 45 ngày tuổi: Ở giai đoạn này tôm khá nhạy cảm và thức ăn tôm thường là các vi sinh vật phù du. Chính vì vậy, người nuôi cần nên cân nhắc và sử dụng thuốc diệt khuẩn khi thực sự cần thiết để đảm bảo cho tôm không bị sốc và chết đi.
– Diệt khuẩn giai đoạn từ 45 ngày tuổi đến khi thu hoạch: Ở giai đoạn này tuy tôm có sức chống chịu cao hơn với giai đoạn trước nhưng cũng không nên sử dụng diệt khuẩn bừa bãi sẽ ảnh hưởng đến sức khỏe tôm.
Các tiêu chí cần xem xét trước khi diệt khuẩn cho ao nuôi tôm
Để chọn chất diệt khuẩn phù hợp, người nuôi cần lưu ý những tiêu chí quan trọng sau:
– Xác định rõ ràng cơ chế hoạt động và khả năng tác động của hóa chất đó lên mầm bệnh (mạnh, trung bình, yếu).
– Các chất hữu cơ ảnh hưởng đến hoạt động diệt khuẩn ra sao.
– Mất bao lâu để chất diệt khuẩn tiếp xúc với mầm bệnh để tiêu diệt mầm bệnh hiệu quả.
– Tác dụng khử trùng/diệt khuẩn có thể kéo dài bao lâu thì phù hợp

Trên đây là các thông tin về vấn đề diệt khuẩn tại ao nuôi. Khi người nuôi quản lý và kiểm soát được khuẩn tốt thì sẽ tăng khả năng thành công trong quá trình nuôi. Việc chủ động kiểm tra thường xuyên, phát hiện và diệt khuẩn sớm sẽ ít ảnh hưởng đến tôm trong ao nuôi. Việc chọn lựa đúng các biện pháp và thời gian diệt khuẩn cũng góp phần quan trọng dẫn đến thành công của vụ nuôi.
—————————————–
Liên hệ: Ms Hương 0936 115 698 (call, zalo)
Giao hàng toàn quốc
Địa chỉ nhà máy: Thanh Sơn – Kim Bảng – Hà Nam.
Website: voicongnghiep.com.vn








